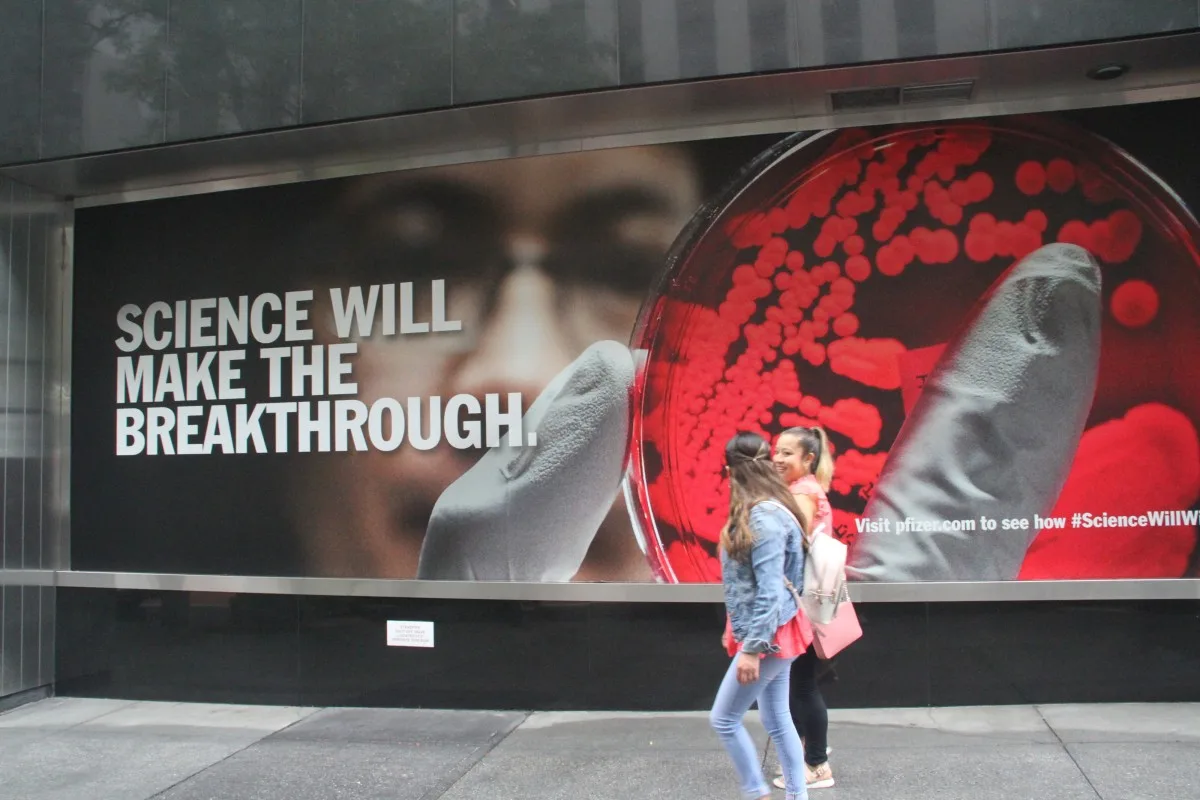

O campo de diagnósticos está avançando mais rápido do que nunca, e o ensaio imunoenzimático (ELISA) continua sendo uma peça fundamental nessa evolução. À medida que novos patógenos surgem e antigos sofrem mutações, cientistas recorrem a esses testes para possibilitar uma detecção precoce e salvar vidas. Abaixo estão sete ameaças crescentes nas quais kits ELISA aprimorados poderiam fazer toda a diferença.
Tabela de Conteúdo
1 – Variantes do Mpox (Varíola dos Macacos)
O Mpox voltou às manchetes, e testes rápidos e precisos são agora essenciais. Kits ELISA estão sendo refinados para detectar anticorpos contra variantes emergentes do Mpox, proporcionando aos profissionais de saúde uma maneira confiável de diagnóstico precoce. Essa identificação variante por variante não só auxilia no tratamento, como também fornece aos epidemiologistas mapas claros sobre como e onde o vírus está se espalhando.
2 – Síndrome da COVID Longa
Talvez um dos desafios mais misteriosos pós-pandemia, a COVID Longa afeta milhões de pessoas em todo o mundo. Painéis ELISA direcionados estão começando a revelar proteínas inflamatórias e anticorpos autoimunes associados a esses sintomas persistentes. Se esses testes se mostrarem confiáveis, poderão fornecer aos médicos sinais mensuráveis em vez de palpites ao diagnosticar essa condição evasiva.
3 – Infecções por Candida auris
A Candida auris recebeu o título de superbactéria porque escapa da maioria dos antifúngicos padrão e se espalha silenciosamente pelos hospitais. Kits ELISA específicos para antígenos da C. auris poderiam permitir que as equipes rastreassem pacientes já na admissão, detectassem infecções precocemente e interrompessem possíveis surtos.
4 – Febre Hemorrágica da Crimeia-Congo (CCHF)
O aquecimento global está levando carrapatos portadores da CCHF para regiões onde nunca existiram, elevando o número de casos. Ferramentas diagnósticas baseadas em ELISA poderiam fornecer testes rápidos e práticos para áreas remotas onde esse vírus transmitido por carrapatos está surgindo, permitindo tratamento mais rápido e medidas de contenção eficazes.
5 – Doença por Vírus Marburg
Surtos recentes na África destacaram a necessidade de melhores diagnósticos para o vírus Marburg. Kits ELISA desenvolvidos para detectar infecções em estágio inicial poderiam transformar as respostas a surtos, permitindo isolamento e tratamento mais rápidos antes que a doença avance para estágios mais graves.
6 – Encefalite pelo Vírus Nipah
Com a mudança nas populações de morcegos frugívoros devido ao desmatamento e às mudanças climáticas, o vírus Nipah está surgindo em novas regiões. Ferramentas de vigilância baseadas em ELISA poderiam ajudar a identificar infecções em populações humanas e animais, criando um sistema de alerta precoce para possíveis surtos.
7 – Biomarcadores da Tuberculose Resistente a Medicamentos
Embora a tuberculose não seja nova, as cepas resistentes a medicamentos estão evoluindo rapidamente. Kits ELISA direcionados a marcadores específicos de resistência poderiam ajudar médicos a escolher tratamentos adequados desde o início, potencialmente melhorando os resultados e reduzindo o desenvolvimento de novas resistências.
O Futuro da Detecção de Doenças Está Aqui
Essas sete doenças emergentes representam apenas a ponta do iceberg em termos de desafios diagnósticos enfrentados pela medicina moderna. A versatilidade, custo-benefício e escalabilidade da tecnologia ELISA a tornam uma plataforma ideal para atender a essas necessidades diagnósticas complexas.
A beleza do ELISA está em sua adaptabilidade – à medida que novos patógenos surgem ou os existentes evoluem, pesquisadores podem rapidamente desenvolver testes específicos para permanecer à frente. Essa capacidade de resposta rápida é exatamente o que precisamos em nosso mundo interconectado, onde doenças podem se espalhar globalmente em questão de horas.
Aja para Melhores Diagnósticos
A luta contra doenças emergentes exige ferramentas diagnósticas avançadas. Se você é pesquisador, clínico ou profissional de saúde pública, a solução ELISA certa pode ser a chave para seu próximo avanço. Navegue em nosso extenso catálogo hoje e junte-se à vanguarda da inovação na detecção de doenças.